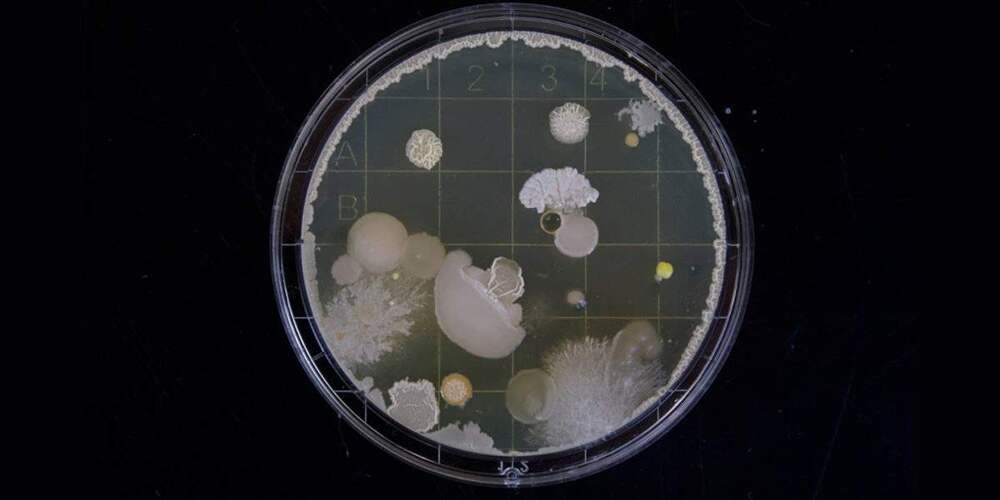

РАЗБОРКИ У КВЖД: ПЕРВЫЙ БОЙ СОВЕТСКИХ ТАНКОВ
Девяносто лет назад в бой впервые пошли советские танки. Где, с кем и как учился современной войне Советский Союз — в нашей статье.
Дорога, которую выбирают все КВЖД, она же Китайско-Восточная железная дорога, была построена на северо-востоке Китая ещё при Николае II и «по наследству»
...ДалееДорога, которую выбирают все КВЖД, она же Китайско-Восточная железная дорога, была построена на северо-востоке Китая ещё при Николае II и «по наследству»